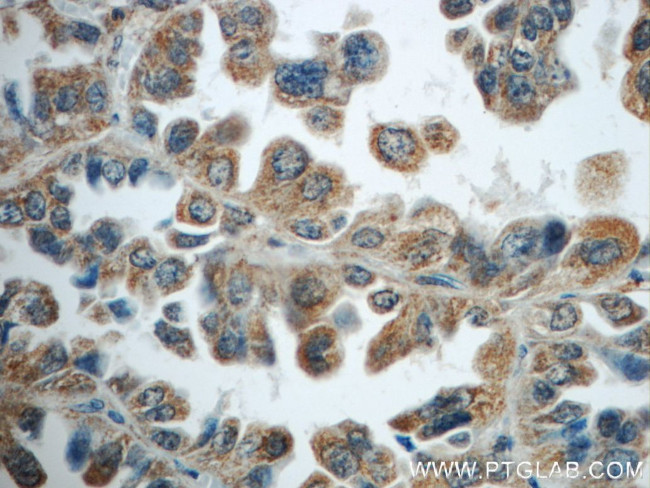
TNFAIP8 Antibody in Immunohistochemistry (Paraffin) (IHC (P))

Search
Proteintech
TNFAIP8 Polyclonal Antibody
{{$productOrderCtrl.translations['antibody.pdp.commerceCard.promotion.promotions']}}
{{$productOrderCtrl.translations['antibody.pdp.commerceCard.promotion.viewpromo']}}
{{$productOrderCtrl.translations['antibody.pdp.commerceCard.promotion.promocode']}}: {{promo.promoCode}} {{promo.promoTitle}} {{promo.promoDescription}}. {{$productOrderCtrl.translations['antibody.pdp.commerceCard.promotion.learnmore']}}
产品信息
15790-1-AP
种属反应
已发表种属
宿主/亚型
分类
类型
抗原
偶联物
形式
浓度
规格
纯化类型
保存液
内含物
保存条件
运输条件
产品详细信息
Immunogen sequence: MHSEAEESK EVATDVFNSK NLAVQAQKKI LGKMVSKSIA TTLIDDTSSE VLDELYRVTR EYTQNKKEAE KIIKNLIKTV IKLAILYRNN QFNQDELALM EKFKKKVHQL AMTVVSFHQV DYTFDRNVLS RLLNECREML HQIIQRHLTA KSHGRVNNVF DHFSDCEFLA ALYNPFGNFK PHLQKLCDGI NKMLDEENI (1-198 aa encoded by BC007014 )
靶标信息
TNFalpha-IP 8 (tumor necrosis factor, alpha-induced protein 8), also known as NFkappa B-inducible DED-containing protein (NDED), SCC-S2 or TNF-induced protein GG2-1, is a 198 amino acid cytoplasmic protein induced by NFkappa B and TNF. The induction of TNFalpha-IP 8 by TNF is dependent on the activation of NFkappa B. TNFalpha-IP 8 negatively mediates apoptosis and may also play a role in tumor progression. TNFalpha-IP 8 specifically inhibits caspase-8 activity, which results in the inhibition of BID cleavage and caspase-3 activation during TNF-mediated apoptosis. TNFalpha-IP 8 is expressed at high levels in thymus, bone marrow, lymph node, spleen, thyroid, placenta and various tumor tissues, as well as fetal lung, liver and kidney. TNFalpha-IP 8 is present as three isoforms produced by alternative splicing.
仅用于科研。不用于诊断过程。未经明确授权不得转售。
生物信息学
蛋白别名: Head and neck tumor and metastasis-related protein; MDC-3.13; MDC-3.13/2; MDC3.13; NDED; NF-kappa-B-inducible DED-containing protein; SCC S2; SCC-S2; TNF alpha-induced protein 8; TNF-induced protein; TNF-induced protein GG2-1; TNFAIP8; TNFalpha IP8; TNFalpha-IP 8; TNFalphaIP8; Tumor necrosis factor alpha-induced protein 8; tumor necrosis factor, alpha induced protein 8; unnamed protein product
基因别名: AA987150; E130304C20Rik; ENSMUSG00000073567; GG2-1; Gm10539; MDC-3.13; NDED; SCC-S2; SCCS2; Ssc-2; TNFAIP8
UniProt ID: (Human) O95379, (Mouse) Q921Z5
Entrez Gene ID: (Human) 25816, (Mouse) 106869, (Rat) 307428